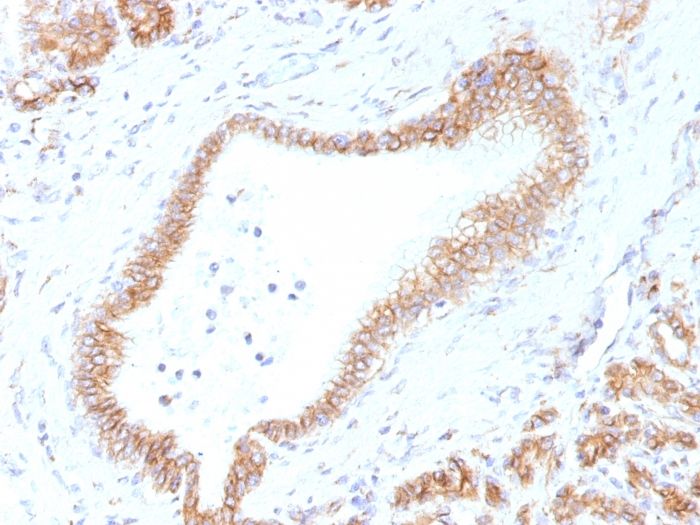

Formalin-fixed, paraffin-embedded human Tonsil stained with Beta-Catenin (p120) Monoclonal Antibody (CTNNB1/1507).
Formalin-fixed, paraffin-embedded human Pancreas stained with Beta-Catenin (p120) Monoclonal Antibody (CTNNB1/1507).

Formalin-fixed, paraffin-embedded Mouse Colon stained with Beta-Catenin (p120) Monoclonal Antibody (CTNNB1/1507).
Beta-catenin associates with the cytoplasmic portion of E-cadherin, which is necessary for the function of E-cadherin as an adhesion molecule. In normal tissues, beta-catenin is localized to the membrane of epithelial cells, consistent with its role in the cell adhesion complex. In breast ductal neoplasia, beta-catenin is usually localized in cellular membranes. However, in lobular neoplasia, a marked redistribution of beta-catenin throughout the cytoplasm results in a diffuse cytoplasmic pattern. Immuno-staining of beta-catenin and E-cadherin is helps in the accurate identification of ductal and lobular neoplasms, including a distinction between low-grade ductal carcinoma in situ (DCIS) and lobular carcinoma. Additionally, some rectal and gastric adenocarcinomas demonstrate diffuse cytoplasmic beta-catenin staining and a lack of membranous staining, mimicking the staining pattern observed with lobular breast carcinomas.
There are no reviews yet.